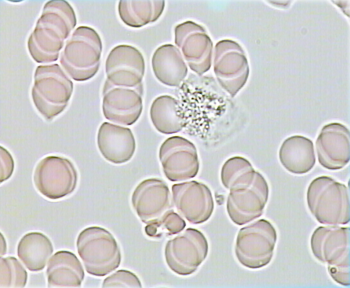

|
В этом разделе мы разместили несколько изображений, которые показывают эффективность лечения различных заболеваний аппаратом СЕМ ТЕСН. Оценка сделана с помощью метода термодиагностики. Зоны желтого цвета показывают воспалительные процессы.
Эффективность лечения остеохондроза позвоночника
 |
 |
| до лечения |
после курса лечения |
Эффективность лечения пневмонии
 |
 |
| до лечения |
после курса лечения
|
Эффективность лечения артрита
 |
 |
| до лечения |
после курса лечения
|
Эффективность лечения при тимусзависимом иммунодефиците
 |
 |
| до лечения |
после курса лечения
|
Подчелюстной лимфаденит после экстракции зубов
 |
 |
| до лечения |
после курса лечения
|
Эффективность воздействия аппарата на кровь человека
На примерах наглядно можно увидеть эффект от 10 минутного воздействие КВЧ волнами на организм: склеянных эритроцитов становится меньше, вязкость крови уменьшается и т.д.
| До воздействия аппаратом |
После воздействия |
 |
 |
|
|
 |
|
Эффективность лечения заболеваний лимфатической системы
После 10 минут воздействия в режиме КВЧ
Восстановление после травмы
Травма произошла в феврале 2009 года. Работая на фуганке мужчина отрубил часть фаланги, врачи отрубленный кусочек пришили. Основная терапия по восстановлению проходила с использованием прибора СЕМ ТЕСН.
Последние фотографии датированы 15 мая 2009 года.
СЕМ ТЕСН подавляет рост грибков
|